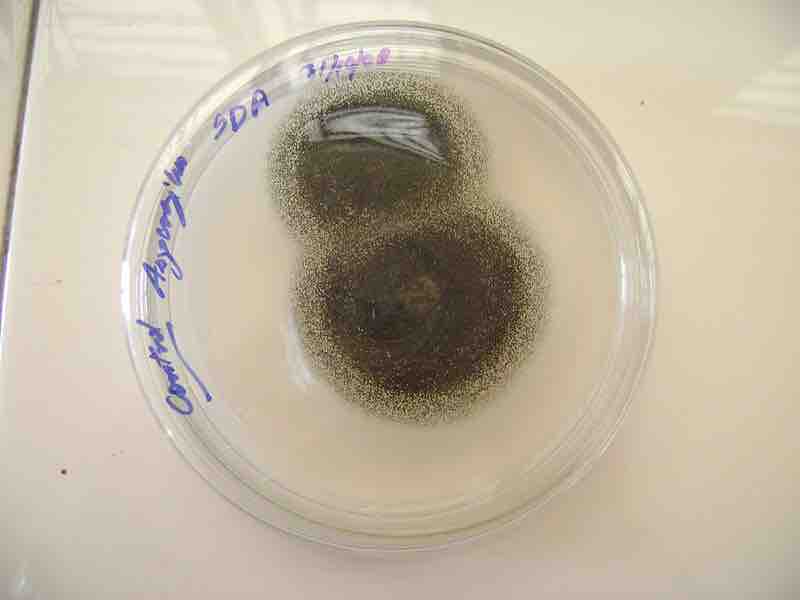

Concept
Version 6
Created by Boundless
Citric Acid and Other Organic Compounds
Colonies of Aspergillus niger
The black dots covering the colonies are Aspergillus spores. The growth medium is Saboraud's Dextrose Agar (SDA)
Source
Boundless vets and curates high-quality, openly licensed content from around the Internet. This particular resource used the following sources:
"Aspergillus niger on SDA."
http://en.wikipedia.org/wiki/File:Aspergillus_niger_on_SDA.JPG
Wikipedia
CC BY-SA.